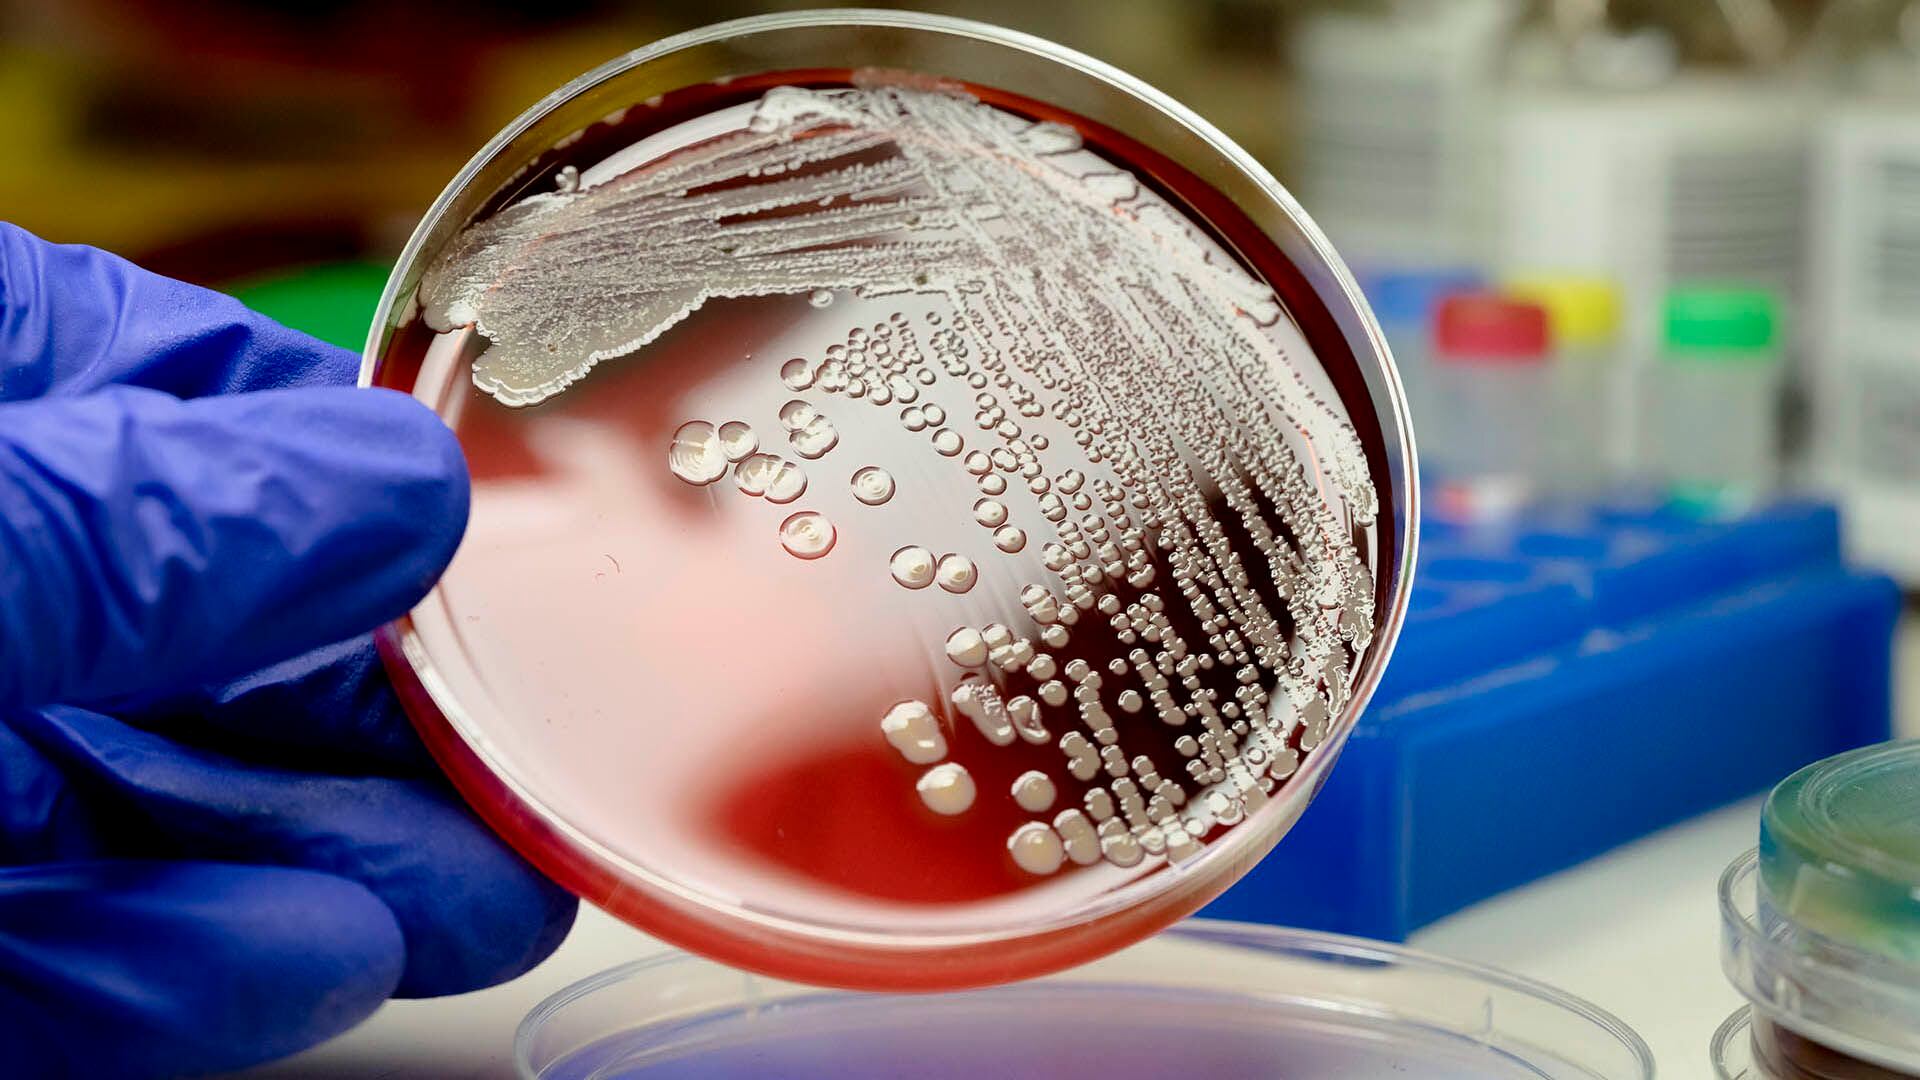

Esta enfermedad inflama los tejidos cerebrales y puede llegar a ser mortal en algunos casos, según la OMS. Puede ser provocada por diversas bacterias y virus. La importancia de la prevención, en la voz de los especialistas.
Este jueves 5 de octubre se conmemora el Día Mundial contra la Meningitis, con el objetivo de concientizar a la población sobre la importancia de esta enfermedad y su prevención. Según la Organización Mundial de la Salud (OMS), “la meningitis es la inflamación de los tejidos que rodean el cerebro y la médula espinal. Suele deberse a una infección, puede ser mortal y requiere atención médica inmediata”.
Hay varias especies de bacterias, virus, hongos y parásitos que pueden causarla. La mayoría se transmite entre personas; mientras que los traumatismos, el cáncer y los medicamentos causan un pequeño número de casos. De acuerdo a la Asociación Española contra la Meningitis, “la meningitis puede ser de origen vírico, que suele ser benigna y de consecuencias leves o de origen bacteriano, que es la más peligrosa”.
“Fundamentalmente hay 3 tipos de bacterias causantes de meningitis, la Haemophilus Influenzae B (HiB), el neumococo y el meningococo con todos sus serogrupos (A, B, C, W, X e Y)”, resaltan desde la entidad española. Mientras que desde la OMS agregan: “La meningitis puede afectar a personas de cualquier edad”.
La meningitis bacteriana, el meningococo (Neisseria meningitidis), también puede ocasionar otro cuadro grave que se conoce como Enfermedad Meningocócica Invasiva (EMI), que se caracteriza por la invasión del meningococo en el torrente sanguíneo, el cual puede propagarse de una persona a otra a través de la saliva o las secreciones respiratorias, especialmente en situaciones donde hay un contacto cercano, como compartir utensilios, estornudar o besarse. Es por esto, y por su sistema inmune inmaduro, que los lactantes (menores de 1 año) y niños menores de 5 años conforman el principal grupo de riesgo de contraer la enfermedad.
 Ricardo Teijeiro, infectólogo, resaltó la importancia de diagnosticar la meningitis tempranamente (Getty)
Ricardo Teijeiro, infectólogo, resaltó la importancia de diagnosticar la meningitis tempranamente (Getty)“Alrededor de una de cada 10 personas que contraen este tipo de meningitis muere y una de cada cinco presenta complicaciones graves”, detalla el máximo ente sanitario internacional, siendo que en 2020 puso en marcha “la hoja de ruta mundial ‘Acabar con la Meningitis para 2030′”.
El doctor Eduardo López, médico especialista en infectología pediátrica y profesor de pediatría y vacunología de la Facultad de Medicina de la USAL, destacó en un comunicado que “la meningitis es una infección grave que evoluciona muy rápidamente. Incluso con un tratamiento adecuado, uno de cada cinco pacientes pueden fallecer entre las primeras 24 a 48 horas de la aparición de los síntomas. Por eso, la vacunación temprana es fundamental para prevenir la enfermedad”.
“Las meningitis en Argentina afectan a chicos menores de 4 años y la meningitis por meningococo afecta a chicos menores de un año, por eso es tan necesaria la vacunación a edades tempranas. Hay que recordar que la mortalidad de esta enfermedad es mayor en niños pequeños, entre el 10 y 15 por ciento de los casos, pero su mayor complicación son las secuelas que quedan en el 25 o 30 por ciento”, planteó López.
De los pacientes que sobreviven a los cuadros graves de meningitis, algunos de ellos pueden tener secuelas permanentes como pérdida de la capacidad auditiva; complicaciones en la piel, a nivel neurológico, psicosociales y psiquiátricas; fallos renales que pueden requerir diálisis; o pérdida de una o más extremidades.
 La meningitis puede ser causada por bacterias, virus, hongos y parásitos, y se transmite entre personas. La bacteria Streptococcus pneumoniae bacteria puede ser una de las causantes
La meningitis puede ser causada por bacterias, virus, hongos y parásitos, y se transmite entre personas. La bacteria Streptococcus pneumoniae bacteria puede ser una de las causantesEnrique Casanueva, jefe emérito y consultor del Servicio de Infectología Infantil, en el Hospital Universitario Austral, afirmó en un comunicado que “los padres son el eslabón fundamental para que un niño esté bien vacunado. Por eso es necesario que tengan claro los beneficios y la seguridad de las vacunas que recibirán sus hijos. Los pediatras debemos escucharlos y luego informar de forma clara sobre las enfermedades que se previenen, su gravedad y sus consecuencias, así como las vacunas disponibles y el momento de aplicación”.
“Si bien la mayoría de las vacunas se aplican en los primeros años de vida, es importante conocer que a lo largo de la vida siguen siendo necesarias porque ayudan al sistema inmunitario a combatir las infecciones de manera más eficiente, provocando una respuesta inmunitaria a enfermedades específicas”, añadió Casanueva.
Según los expertos de Mayo Clinic, “los síntomas iniciales de la meningitis pueden ser similares a los de la gripe, y pueden manifestarse durante varias horas o unos días”. Estos pueden ser fiebre alta repentina; rigidez en el cuello; dolor de cabeza intenso; náuseas o vómitos; confusión o dificultad para concentrarse; convulsiones; somnolencia o dificultad para despertarse; sensibilidad a la luz; falta de apetito o de sed; y erupción cutánea en algunos casos, como en la meningitis meningocócica.
La meningitis puede afectar a personas de cualquier edad, advierten desde la OMS
La meningitis puede afectar a personas de cualquier edad, advierten desde la OMSA su vez, de acuerdo a Mayo Clinic, los principales factores de riesgo de esta enfermedad son los siguientes:
-La edad. La mayoría de los casos de meningitis viral se produce en niños menores de 5 años. En tanto, la meningitis bacteriana es frecuente en los menores de 20 años.
-Un sistema inmunitario comprometido. El SIDA, el alcoholismo, la diabetes, el uso de medicamentos inmunosupresores y otros factores que afectan al sistema inmunitario también pueden hacerte más vulnerable a la meningitis. La extirpación del bazo también aumenta tu riesgo, y cualquier persona que no tenga bazo debe vacunarse para
-Embarazo. El embarazo aumenta el riesgo de listeriosis, una infección causada por la bacteria listeria, que también puede causar meningitis. La listeriosis aumenta el riesgo de aborto espontáneo, muerte fetal en el útero y parto prematuro.
-Algunos entornos comunitarios. Por ejemplo, los estudiantes universitarios que viven en residencias estudiantiles, el personal en bases militares y los niños en internados y centros asistenciales infantiles corren un mayor riesgo de contraer meningitis meningocócica. Probablemente esto se deba a que la bacteria se propaga por la vía respiratoria y a través de grandes grupos.

Anteriormente, en diálogo con Infobae, Ricardo Teijeiro (MN 58065), infectólogo del Hospital Pirovano y miembro de la Sociedad Argentina de Infectología (SADI), había explicado que “la meningitis es una inflamación de la meninge, que es el tejido que cubre al sistema nervioso central en todo su trayecto. En el medio de las meninges está el líquido cefalorraquídeo, que es lo que nosotros punzamos y podemos hacer diagnóstico”.
“Los síntomas, en general, son muy parecidos. El dolor de cabeza, la fiebre y el malestar general. Ahora, cada meningitis va a tener individualidad en algunos síntomas y, sobre todo, en los tratamientos, por eso es muy importante diagnosticarla lo más temprano posible”, resaltó Teijeiro.
Y sumó: “La meningitis bacteriana por el meningococo, por el neumococo, o por haemophilus influenzae tratada con antibiótico tempranamente evoluciona muy bien y rápido. Si no pueden ser mortales o dejar grandes secuelas, por eso tenemos que tener muy claro que todo este tipo de patologías tienen que ser rápidamente diagnosticadas para que el paciente tenga una muy buena evolución”.
“Cuando hay un contacto estrecho -dijo Teijero-, lo que hay que hacer, si es una meningitis por meningococo, por ejemplo, es dar un tratamiento que serán muy pocas tomas: a veces dos o cuatro, según corresponda de acuerdo al germen y a los que estuvieron en contacto. Hay meningitis y etiologías de este tipo que tienen mecanismos de prevención, como las vacunas. Hay vacuna para neumococo, para meningococo o para alguna de las cepas de meningococo, para haemophilus, para tuberculosis. Esa es la manera de prevención en general”.